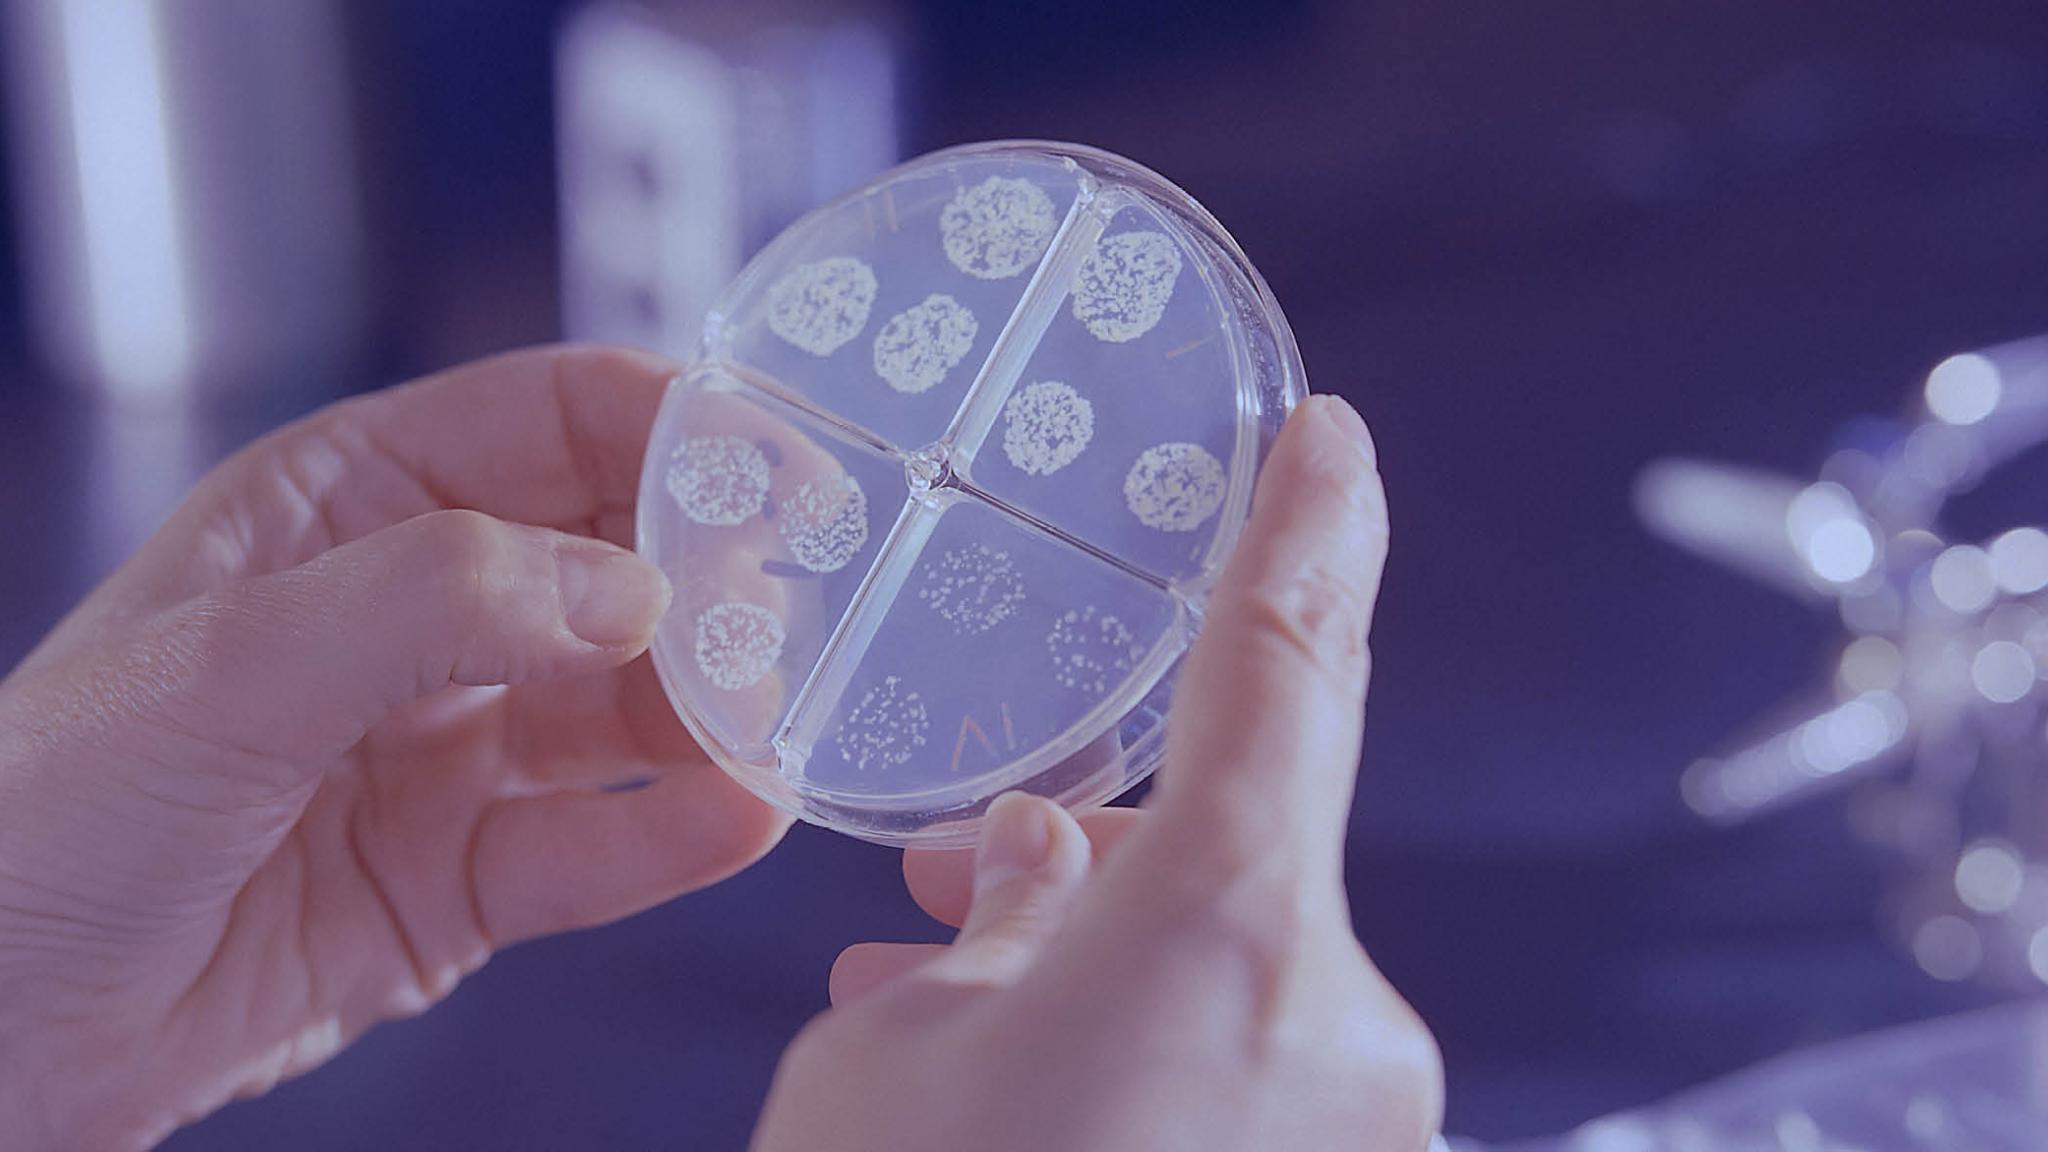
title

TBC-incidentie in 2021 iets gestegen in Nederland
In Nederland zijn er in 2021 9% meer mensen gediagnostiseerd met tuberculose (TBC) dan in 2020. Omdat het aantal besmettingen alsnog 10% lager is dan in 2019, past dit nog steeds bij de ontwikkeling van de afgelopen 20 jaar, waarin TBC-indecentie in Nederland steeds kleiner wordt, volgens het surveillancerapport van het RIVM.
In 2021 werden 680 mensen met TBC gemeld, terwijl dat er in 2020 622 waren. Door de pandemie was het aantal besmettingen in 2020 opvallend laag. Gedacht wordt dat de TBC-bacterie zich minder goed kon verspreiden door de coronamaatregelen, zoals persoonlijke hygiëne en afstand bewaren. Ook kan de druk op de gezondheidszorg door COVID-19 voor vertraging in TBC-diagnostiek hebben gezorgd. Het is mogelijk dat dit minder van invloed was in 2021.
De TBC-incidentie was in 2021 4,0 per 100.000 inwoners. De doelstelling uit het Nationaal Plan Tuberculosebestrijding is een incidentie 2,6 per 100.000. Hiervoor is de komende jaren dus nog een sterke daling nodig.
Ruim de helft van de patiënten (56 procent) had pulmonale tuberculose of een combinatie van pulmonale en extrapulmonale tuberculose. TBC-meningitis kwam in 2021 bij twintig patiënten voor.
Wilt u op de hoogte blijven van Nederlands nieuws op het gebied van tuberculose? Schrijf u in voor de Tegen de Tuberculose Nieuwsbrief.